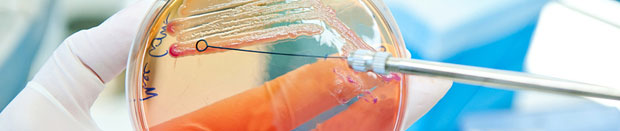

Im Moment bieten wir im Bereich Mikrobiologie/Virologie/Hygiene folgende Übersichten an:
2025
Tabellen mit Nachweissystemen für neurotrope Erreger (Heft 1/2025)
2024
Resistenztestung in der Mikrobiologie (Heft 4/2024)
Respiratorische Infektionen (inkl. Tabellen mit Nachweissystemen) (Heft 4/2024)
Tabellen mit Nachweissystemen für gastrointestinale Infektionen (Heft 3/2024)
Tabellen mit Nachweissystemen für sexuell übertragbare Infektionen (STI) (Heft 1/2024)
2023
Nachweissysteme für respiratorische Erreger (Heft 4/2023)
Tropeninfektion und vektorübertragene Krankheiten (Heft 3/2023)
SARS-CoV-2 – Ein Erreger von vielen? (mit tabellarischer Übersicht) (Heft 2/2023)
2022
Diagnostik von Atemwegsinfektionen: Zeit der respiratorischen Erreger (Heft 4/2022)
2022
Diagnostik von Atemwegsinfektionen: Zeit der respiratorischen Erreger (Heft 4/2022)
SARS-CoV-2: Logbuch der Corona-Pandemie (Heft 1/2022)
2021
SARS-CoV-2-Diagnostik: Testen, Testen und nochmal Testen (Heft 1/2021)
Nosokomiale Infektionen: Resistente bakterielle Erreger (Heft 2/2021)
Begleitdiagnostik COVID-19: Fünf Assays – fünf Erkenntnisse (Heft 2/2021)
HPV-Diagnostik: Ein bunter Methodenstrauß (Heft 3/2021)
2020
Diagnostik von respiratorischen Infektionen (Heft 4/2020)
Automation in der Mikrobiologie (Heft 4/2020)
Gastrointestinale Erreger (Heft 3/2020)
Tuberkulose-Diagnostik (Heft 2/2020)
Nachweissysteme für SARS-CoV-2 und Antikörper (Heft 2/2020)
Sexuell übertragbare Infektionen (Heft 1/2020)
2019
Sepsisdiagnostik (Heft 3/2019)
Komplettsysteme für den Nukleinsäurenachweis in der Mikrobiologie (Heft 1/2019)
2018
Influenza-Tests im Überblick (Heft 4/2018)
Nachweis nosokomialer Infektionen (Heft 4/2018)
Kompakte NAT-Automaten für die Mikrobiologie (Heft 4/2018)
Biomarker für zerebrale Erkrankungen (Heft 1/2018)
2017
Molekularbiologische Tuberkulose-Assays (Heft 4/2017)
Tests und Gerätesysteme für den Nachweis sexuell übertragbarer Infektionen (Heft 3/2017)
Automations- und IT-Systeme für die Mikrobiologie (Heft 3/2017)
Biomarker der Infektion und Entzündung (Heft 2/2017)
2016
Systeme und Tests für die Virusdiagnostik (Heft 3/2016)
Produktübersicht Erreger- und Resistenznachweis (Heft 2/2016)
Testsysteme für die Infektions- und Sepsisdiagnostik (Heft 1/2016)
2015
Influenzatests im Überblick (Heft 4/2015)
Gastrointestinale Infektionen (Heft 2/2015)
MALDI-TOF Massenspektometrie (Heft 2/2015)
2014
Respiratorische Infektionsdiagnostik (Heft 4/2014)
Sexuell übertragbare Erkrankungen (Heft 3/2014)
Tuberkulosediagnostik (Heft 2/2014)
Molekulare Infektionsdiagnostik (Heft 2/2014)
Borreliendiagnostik (Heft 1/2014)
2013
Resistenztestung (Heft 2/2013)
Chronisch entzündliche Darmerkrankungen (Heft 4/2013)
Sepsisdiagnostik (Heft 1/ 2013)
2012
Automationssysteme für die Mikrobiologie (Heft 2/2012)
2011
Borreliendiagnostik (Heft 1/2011)